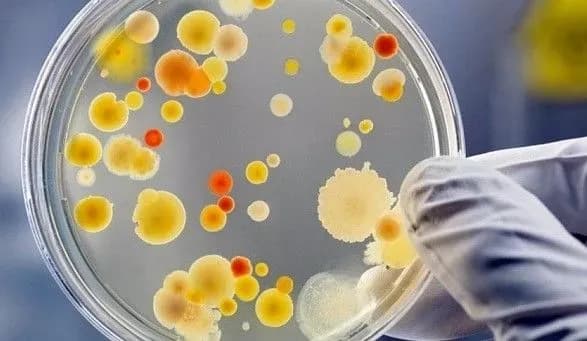
Діагноз ботулізм підтвердили у чотирьох людей на Кіровоградщині

Діагноз ботулізм підтвердили у чотирьох людей на Кіровоградщині
Київ • УНН
КИЇВ. 24 липня. УНН. За перше півріччя 2018 року на Кіровоградщині діагноз ботулізм підтвердили у чотирьох осіб. Про це кореспонденту УНН повідомила заступник директора Кіровоградського обласного лабораторного центру Надія Оперчук.
“У нас було п’ять підозр, на сьогодні чотири підтверджено, один діагноз зняли. Усі захворілі пролікувалися і були виписані з лікувальних закладів”, — сказала вона.
Всі захворілі — дорослі. Двоє чоловіків вживали домашнє консервоване сало та паштети. Подружжя з Онуфріївського району заразилося у Кременчуку. Люди вживали в’ялену рибу.
Ботулізм — важке токсичне інфекційне захворювання, у результаті якого вражається нервова система. Важка форма захворювання може призвести до летального результату. Найчастіше інфекція ботулізму міститься у таких продуктах як гриби домашнього консервування, копчена або в’ялена риба, м’ясні і ковбасні вироби, бобові консерви.
Нагадаємо, в Україні з початку року зареєстрували вже 58 випадків ботулізму, п'ять з них - летальні.